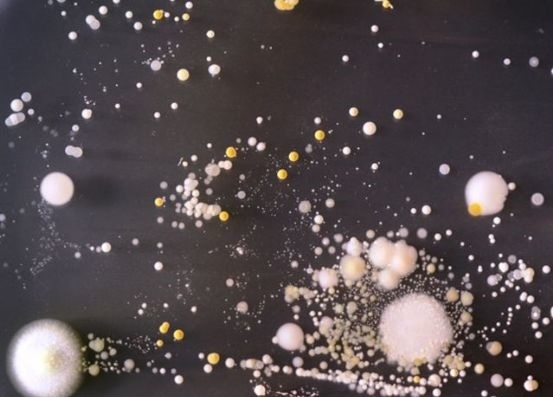
Cep telefonu kullananlar dikkat! galerisi resim 3

Cep telefonu kullananlar dikkat!
01 Nisan 2016 Cuma 15:08Üniversitede süren çalışmalar sırasında bakteriler fotograflandı ve bu görüntüler büyütüldü. Bu bakterilerin tümü, iğrenç görünmelerine karşın zararlı değil. Ancak, Staphylococcus aureusgibi tehlikeli bazı bakteriler de telefonlarda görülebiliyor. Bu bakteri, “Hastane infeksiyonu” olarak adlandırılıyor. Akıllı telefonların klavye ve benzeri bir dizi tuşa sahip olması, daha çok bakteri taşımalarına neden oluyor. Eski tip telefonlar bu nedenle daha az pis olabilir.
Tüm Hakları Saklıdır © 2014 Haberdarım | İzinsiz ve kaynak gösterilmeden yayınlanamaz.
Haber Yazılımı: So Bilişim
Haber Yazılımı: So Bilişim